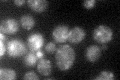
YBL102W
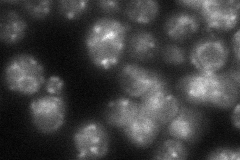
YBL102W
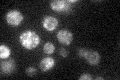
YBL102W

View description
Non-essential tetra-spanning membrane protein found mostly in the late Golgi, can suppress some sed5 alleles; may be part of the transport machinery, but precise function is unknown; similar to mammalian syntaxin 5
Localization:
Intensity:
Fold change:
Significance:
-
C’ GFP library in SD
punctate26.48 -
N' NOP1pr-GFP in SD

punctate131.002 -
N' TEF2pr-mCherry in SD

punctate,vacuole249.051 -
N' NATIVEpr-GFP in SD
punctate54.1986 -
N' TEF2pr-VC and Cyto-VN in SD

punctate46.0298 -
C’ GFP library in SD+DTT

punctate25.010.94No -
C’ GFP library in SD+H2O2

punctate27.321.03No -
C’ GFP library in Starvation Media
punctate25.690.96No -
C’ GFP library on the background of Pup2-DaMP

punctate -
C’ GFP library on the background of CCT mutant

punctate22.35490.843984No
